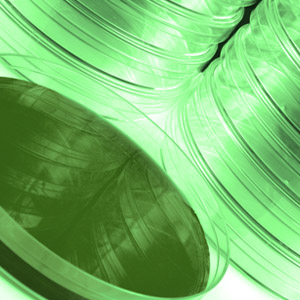
Petri-dishes for microbiology

Which standard product would you like to enquire about ordering in bulk? Please select 2X LB-Agar 2X LB-Broth 2X VYT Agar 2X VYT Broth 2X YT Agar 2X YT Broth 3-Amino-1,2,4-Triazole, 3-AT 5-Aminolevulinic acid hydrochloride 5-Fluoro Orotic Acid Monohydrate A Medium Adenine sulphate Agar Agar Granulated, Bacteriological grade AIM – 2YT Broth Base including Trace elements AIM – 2YT Broth Base w/o Trace elements AIM – LB Broth Base including Trace elements AIM – LB Broth Base w/o Trace elements AIM – Super Broth Base including Trace elements AIM – Super Broth Base w/o Trace elements AIM – Terrific Broth Base including Trace elements AIM – Terrific Broth Base w/o Trace elements Ampicillin Sodium AX Medium Blood Agar Base Brent (BSM) Drop Out Carbenicillin Disodium Casamino Acids Cefotaxime Sodium Chloramphenicol Complete Supplement Mix (CSM) Drop Out D(+) – Galactose D(+) – Glucose Anhydrous D(+) – Lactose monohydrate D(+) – Raffinose Pentahydrate D(+) – Sorbitol D(+)-Biotin D(+)-Sucrose Doxycycline Hyclate DTT EDTA Disodium EMM Agar EMM Agar low Dextrose, 5 g/l EMM Agar plus 1 x SP Supplements, -Leu, -Ura EMM Agar without Dextrose EMM Agar without Nitrogen EMM Agar without Phosphates EMM Broth EMM Broth low Dextrose, 5 g/l EMM Broth plus 1 x SP Supplements, -Leu, -Ura EMM Broth without Dextrose EMM Broth without Nitrogen EMM Broth without Phosphates EMM Glutamate Agar EMM Glutamate Broth EMMS FM Amino acid drop-out mixtures FM drop-out mixture, minus Arginine and w/o Cysteine, 7400 mg/l FM drop-out mixture, minus Arginine and w/o Glutamic acid, 7100 mg/l FM drop-out mixture, minus Arginine and w/o Lysine, 6700 mg/l FM drop-out mixture, minus Arginine and w/o Methionine, 7300 mg/l FM drop-out mixture, minus Arginine, 7700 mg/l FM drop-out mixture, minus Cysteine and w/o Glutamic acid, 7600 mg/l FM drop-out mixture, minus Cysteine and w/o Lysine, 7200 mg/l FM drop-out mixture, minus Cysteine and w/o Methionine, 7800 mg/l FM drop-out mixture, minus Cysteine, 8100 mg/l FM drop-out mixture, minus Glutamic acid and w/o Lysine, 6900 mg/l FM drop-out mixture, minus Glutamic acid and w/o Methionine, 7500 mg/l FM drop-out mixture, minus Glutamic acid, 7800 mg/l FM drop-out mixture, minus Lysine and w/o Methionine, 7100 mg/l FM drop-out mixture, minus Lysine, 7400 mg/l FM drop-out mixture, minus Methionine, 8000 mg/l FM Minimal Medium FM Minimal medium w/o Amino acids FM Minimal medium w/o Amino acids and w/o Ammonium chloride FM Minimal medium w/o Arginine and w/o Lysine FM Minimal medium w/o Cysteine and w/o Methionine FM Minimal medium w/o Glutamic acid and w/o Lysine FM Minimal medium w/o Methionine FM Minimal medium w/o NH4Cl G-418 DiSulphate G-418 Solution GAL Indicator Medium Gentamicin Sulphate Glycine HEPES HL5 Medium including Glucose HL5 Medium including Glucose supplemented with vitamins and micro-elements HL5 Medium without Glucose HL5 Medium without Glucose supplemented with vitamins and micro-elements HL5-C Medium including Glucose HL5-C Medium including Glucose supplemented with vitamins and micro-elements HL5-C Medium without Glucose HL5-C Medium without Glucose supplemented with vitamins and micro-elements Hollenburg (HSM) Drop Out Hopkins (SCSM) Drop Out Hydroxyurea Hygromycin B (powder) Inositol IPTG Dioxane free Kaiser (SC) Drop Out Kanamycin Disulphate Salt Kanamycin Monosulphate L-Alanine L- Arabinose L-Arginine L-Asparagine. H2O L-Aspartic acid L-Broth L-Broth Agar L-Broth Top Agar L-Cysteine L-Glutamic acid L-Glutamine L-Histidine L-Isoleucine L-Leucine L-Lysine L-Methionine L-Phenylalanine L-Proline L-Serine L-Threonine L-Tryptophan L-Tyrosine L-Valine L(+)- Seleno Methionine LB Agar w/o NaCl LB Broth w/o NaCl LB-Agar Lennox LB-Agar Miller LB-Broth Lennox LB-Broth Miller LB-Top Agar Lennox LB-Top Agar Miller LBM-Agar Lennox LBM-Agar Miller LBM-Broth Lennox LBM-Broth Miller Lee’s Medium LoFlo Medium LoFlo Medium supplemented with Yeast extract M17 Broth M9 Minimal Salts Base, 5x MacConkey Agar Base Malt Extract MAL Indicator Medium Malt Extract Agar MB Agar MB Broth MB Broth without Amino acids ME Agar ME Broth MES – SDS Running Buffer MES Monohydrate MMA Agar Medium MOPS MOPS – SDS Running Buffer Mueller Hinton Broth Nutrient Agar Nutrient Broth NZ Agar NZ Broth NZ Top Agar NZCYM Agar NZCYM Broth NZCYM Top Agar NZY Agar NZY Broth NZYDT Agar NZYDT Broth NZYM Agar NZYM Broth NZYM Top Agar para-Aminobenzoic acid PDA, Potato Dextrose Agar PDB, Potato Dextrose Broth Peptone Phosphate Buffered Saline Potato Extract Pre-Sporulation Medium RNase Sabouraud Agar SC Agar / 2% Galactose SC Agar / 2% Galactose / 1% Raffinose SC Agar / 2% Glucose SC Agar / 2% Raffinose SC Agar / 3.3% Succinate SC Broth / 2% Galactose SC Broth / 2% Galactose / 1% Raffinose SC Broth / 2% Glucose SC Broth / 2% Raffinose SC Broth / 3.3% Succinate SD Agar / 2% Galactose SD Agar / 2% Galactose / 1% Raffinose SD Agar / 2% Glucose SD Agar / 2% Glucose w/o Phosphate (KH2PO4) SD Agar / 2% Raffinose SD Agar / 3.3% Succinate SD Broth / 2% Galactose SD Broth / 2% Galactose / 1% Raffinose SD Broth / 2% Glucose SD Broth / 2% Glucose w/o Phosphate (KH2PO4) SD Broth / 2% Raffinose SD Broth / 3.3% Succinate SDS Micro-Pellets SIH Amino acid drop-out mixture SIH drop-out mixture, minus Arginine and w/o Cysteine, 8195 mg/l SIH drop-out mixture, minus Arginine and w/o Glutamic acid, 7950 mg/l SIH drop-out mixture, minus Arginine and w/o Lysine, 7245 mg/l SIH drop-out mixture, minus Arginine and w/o Methionine, 8145 mg/l SIH drop-out mixture, minus Arginine, 8495 mg/l SIH drop-out mixture, minus Cysteine and w/o Glutamic acid, 8350 mg/l SIH drop-out mixture, minus Cysteine and w/o Lysine, 7645 mg/l SIH drop-out mixture, minus Cysteine and w/o Methionine, 8545 mg/l SIH drop-out mixture, minus Cysteine, 8895 mg/l SIH drop-out mixture, minus Glutamic acid and w/o Lysine, 7400 mg/l SIH drop-out mixture, minus Glutamic acid and w/o Methionine, 8300 mg/l SIH drop-out mixture, minus Glutamic acid, 8650 mg/l SIH drop-out mixture, minus Lysine and w/o Methionine, 7595 mg/l SIH drop-out mixture, minus Lysine, 7945 mg/l SIH drop-out mixture, minus Methionine, 8845 mg/l SIH Medium SIH medium w/o Amino acids SIH medium w/o Amino acids and w/o Ammonium chloride SIH medium w/o Arginine and w/o Lysine SIH medium w/o Cysteine and w/o Methionine SIH medium w/o Glutamic acid and w/o Lysine SIH medium w/o Methionine SIH medium w/o NH4Cl SM Agar SM Agar/5 SM Broth SM Broth/5 SOA SOA, Hanahan’s Agar SOB SOB, Hanahan’s Broth SOC Agar SOC Broth Sodium Chloride Soya Peptone SP Supplements SP Supplements, -Leu, -Ura SP Supplements, -Lys Sporulation Medium STD Agar Super Broth Super Broth Agar Super Broth Top Agar TAE Buffer TBE Buffer TBS Buffered Saline 10X, pH 7.4 TBS Buffered Saline 10X, pH 7.6 TBS Buffered Saline 10X, pH 7.8 TBS Buffered Saline 10X, pH 8.0 Terrific Agar Terrific Agar Phosphate Buffered Terrific Broth Terrific Broth Phosphate Buffered Tetracycline HCl Translucent K+ free medium”, YNB w/o Amino acids and without Ammonium sulphate and w/o Potassium Translucent K+ free medium”, YNB w/o Amino acids and without Ammonium sulphate and w/o Potassium and w/o Folic adid and w/o Riboflavin TRIS Tris Glycine Buffer 10X Tryptic Soy Agar Tryptic Soy Broth Tryptone Tryptone Agar Tryptone Broth Tryptone Top Agar Uracil VL6 Medium including Glucose (Animal Component Free – ACF) VL6 Medium without Glucose (Animal Component Free – ACF) VLB-Agar Lennox VLB-Agar Miller VLB-Broth Lennox VLB-Broth Miller Wallerstein Agar X-Gal YE Agar YE Broth Yeast Carbon Base Yeast Extract, Powder Yeast Mold Agar Yeast Mold Broth Yeast Morphology Agar Yeast Nitrogen Base Yeast Nitrogen Base without Amino acids Yeast Nitrogen Base without Amino acids and without Ammonium sulphate Yeast Nitrogen base without Amino acids and without Biotin Yeast Nitrogen base without Amino acids and without Boron Yeast Nitrogen base without Amino acids and without Calcium Yeast Nitrogen base without Amino acids and without Calcium Pantothenate Yeast Nitrogen base without Amino acids and without Copper Yeast Nitrogen base without Amino acids and without Folic Acid Yeast Nitrogen base without Amino acids and without Folic Acid and Riboflavin. LoFlo Yeast Nitrogen base without Amino acids and without Inositol Yeast Nitrogen base without Amino acids and without Iodine Yeast Nitrogen base without Amino acids and without Iron Yeast Nitrogen base without Amino acids and without Magnesium Yeast Nitrogen base without Amino acids and without Manganese Yeast Nitrogen base without Amino acids and without Molybdene Yeast Nitrogen base without Amino acids and without Nicotinic acid Yeast Nitrogen Base without Amino acids and without para-Amino Benzoic acid Yeast Nitrogen Base without Amino Acids and without Phosphate Yeast Nitrogen Base without Amino Acids and without Phosphate, supplemented with KCl Yeast Nitrogen base without Amino acids and without Pyridoxine Yeast Nitrogen base without Amino acids and without Riboflavine Yeast Nitrogen base without Amino acids and without Sodium Yeast Nitrogen base without Amino acids and without Thiamine Yeast Nitrogen base without Amino acids and without Zinc Yeast Nitrogen Base without Amino acids, without Ammonium sulphate and without para-Amino Benzoic acid Yeast Nitrogen base without Amino acids, without Ammonium sulphate and without Biotin Yeast Nitrogen base without Amino acids, without Ammonium sulphate and without Boron Yeast Nitrogen base without Amino acids, without Ammonium sulphate and without Calcium Yeast Nitrogen base without Amino acids, without Ammonium sulphate and without Calcium Pantothenate Yeast Nitrogen base without Amino acids, without Ammonium sulphate and without Copper Yeast Nitrogen base without Amino acids, without Ammonium sulphate and without Folic Acid Yeast Nitrogen base without Amino acids, without Ammonium sulphate and without Folic Acid and Riboflavine. LoFlo Yeast Nitrogen base without Amino acids, without Ammonium sulphate and without Inositol Yeast Nitrogen base without Amino acids, without Ammonium sulphate and without Iodine Yeast Nitrogen base without Amino acids, without Ammonium sulphate and without Iron Yeast Nitrogen base without Amino acids, without Ammonium sulphate and without Magnesium Yeast Nitrogen base without Amino acids, without Ammonium sulphate and without Manganese Yeast Nitrogen base without Amino acids, without Ammonium sulphate and without Molybdene Yeast Nitrogen base without Amino acids, without Ammonium sulphate and without Nicotinic acid Yeast Nitrogen Base without Amino Acids, without Ammonium sulphate and without Phosphate, supplemented with KCl Yeast Nitrogen base without Amino acids, without Ammonium sulphate and without Pyridoxine Yeast Nitrogen base without Amino acids, without Ammonium sulphate and without Riboflavine Yeast Nitrogen base without Amino acids, without Ammonium sulphate and without Sodium Yeast Nitrogen base without Amino acids, without Ammonium sulphate and without Thiamine Yeast Nitrogen base without Amino acids, without Ammonium sulphate and without Zinc Yeast Nitrogen base without Amino acids, without Ammonium sulphate, without Copper and without Iron Yeast Nitrogen base without Amino acids, without Copper and without Iron Yeast Potassium Nitrate Nitrogen Base Yeast Vitamin Free Base YEP Agar YEP Broth YES Agar YES Broth YGC Agar YPAD Agar YPAD Broth YPD Agar YPD Broth YPL Agar with Lactose YPL Broth with Lactose YSO Agar YSO Broth YT Agar YT Broth YT Top Agar